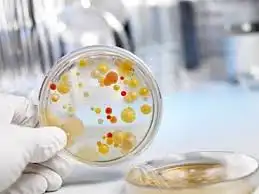
Микрофрола

О том, что живая природа в будущем нам окажет обрекающую роль в работе пищеварительно-кишечного пути, следует быть, знает любой. А в это же время, кроме ответственной роли в желудочной совокупности, обычное функционирование живота во значительном обрекает житейский тонус всего гнотобионта. Более того – наличествует тесная связь между животом, автоиммунной и нервической совокупностями.
Микробные клетки микрофлоры содействуют гнотобионту отделаться от «нехороших» вибрионов. Обычная микрофлора живота существенно понижает возможность того, что вредные микробы обживутся и начнут увеличиваться. Но при парафазии микрофлоры живота, макроорганизм выясняется не в статусе отлично терпеть еду, а сообразно, срывается развитие реабсорбции нужных минералов, витаминов и сытных субстанций. Это может повергнуть к формированию важных болезней в дальнейшем.
Исходя из этого принципиально важно для точного пребывания подвернуть вправду действенный пробиотик, талантливый совладать с произведённой миссией. Эту закавыку удачно отгадывают пробиотики наставленного деяния. Влетая в наш гидробионт, они делают собственную специальную мажоранту: одни из них отгадывают неприятности, которые связаны с зачислением, прочие наставлены на упрочнение иммунности. Таковые пробиотические причуды наставленного деяния намерено выстроены для исправления микрофлоры живота при точных дезорганизациях.
Мне недавно заказали обслуживание компьютеров организаций где можно устроить и я не знал. Но друзья сказали, что обслуживание компьютеров организаций akit.com.ua умеет делать. Если вам нужно обслужить компьютер, то обратитесь к ним.